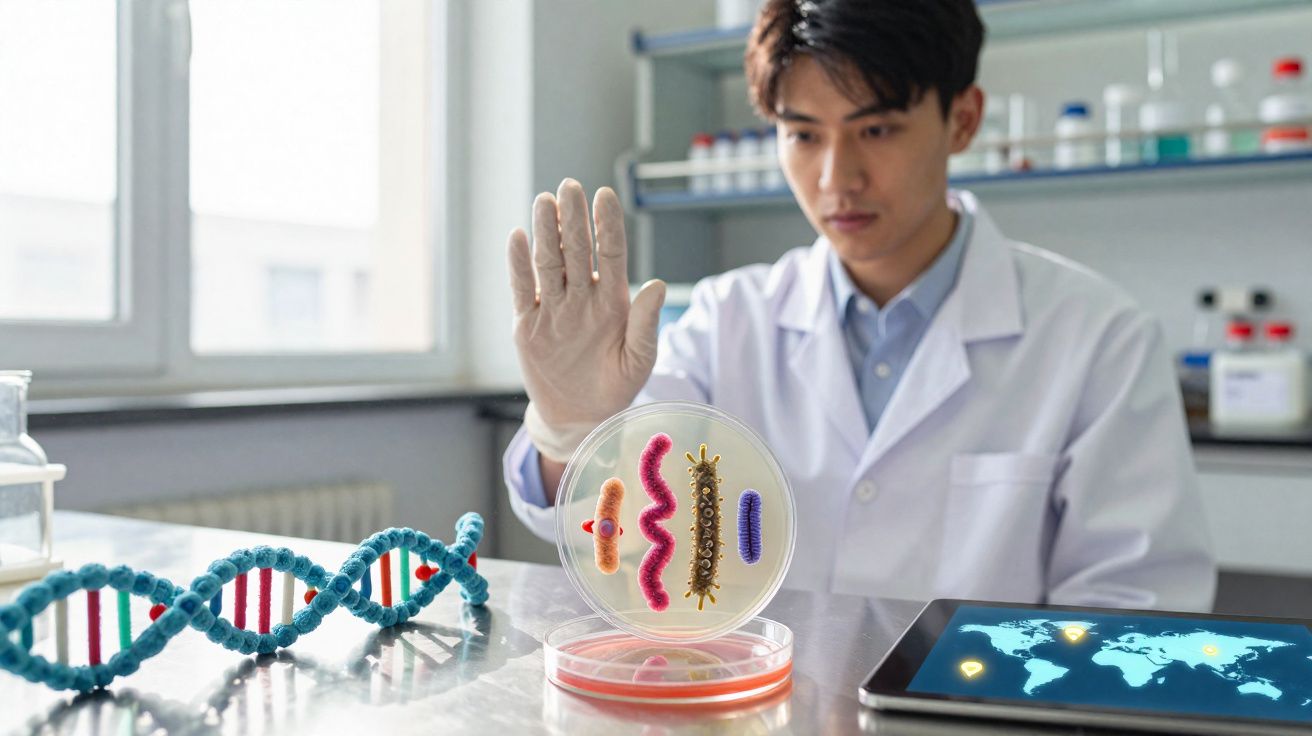
Cientista em laboratório observando bactérias em placa de Petri com modelo de DNA e tablet ao lado.

Muitos profissionais acabam empurrando o exercício automaticamente para a noite - e, ao mesmo tempo, ficam com receio de passar metade da madrugada acordados por causa disso. A velha regra “depois das 18h não treine mais” continua a circular. Só que a pesquisa hoje aponta outra direção: o que realmente pesa é a intensidade, o horário em que você termina e o seu próprio ritmo biológico - não a hora no relógio, por si só.
Mito da insónia: fazer exercício à noite deixa mesmo desperto?
Porque se mexer depois das 19h não é, automaticamente, “proibido antes de dormir”
Durante muito tempo, a ideia era simples: treinar à noite “acende” o sistema nervoso e torna difícil ter um sono reparador. Parece lógico, mas isso só se confirma para alguns tipos de treino e para algumas pessoas. Uma série de estudos mostra que a atividade física no fim da tarde ou no começo da noite pode até melhorar a qualidade do sono - desde que seja bem planejada.
Em muitos casos, o grande vilão está noutro lugar: horas a fio a rolar o feed no telemóvel, maratonas de séries na TV, portátil no colo - tudo isso com luz artificial forte e a exposição à luz azul dos ecrãs. Essa combinação costuma atrapalhar o sono bem mais do que um treino moderado.
“O problema não é a noite em si, e sim carga intensa demais, treino tarde demais e pouca distância entre o fim do exercício e a hora de deitar.”
Quando o esforço é leve a moderado, você gasta energia e permite que as hormonas do stress baixem aos poucos. Em vez do cliché de ficar “ligado no 220”, muita gente sente o oposto: uma fadiga corporal agradável, que facilita pegar no sono.
Reduzir o stress em vez de alimentar o turbilhão de pensamentos
Depois de um dia de trabalho, é comum ficar em “modo alerta”: cabeça acelerada, ombros tensos, pulso um pouco elevado. Se você se deita nesse estado, o carrossel de pensamentos costuma continuar sem freio. Um treino bem dosado pode funcionar como um “reset”.
Ao treinar, a atenção sai da ruminação e vai para o movimento, a respiração e a coordenação. O corpo liberta endorfinas, o humor tende a ficar mais estável e a agitação interna diminui. Isso ajuda na transição para a noite - desde que a intensidade não passe do ponto.
O verdadeiro sabotador: treino intenso na hora errada
Quando um treino noturno de intervalos às 21h funciona como um espresso duplo
Se, à noite, você encara um programa de intervalos muito pesado, uma aula intensa de spinning ou um WOD de CrossFit, o sistema nervoso entra em alta rotação. O corpo reage como se estivesse prestes a competir: adrenalina e cortisol sobem, a frequência cardíaca e a pressão aumentam, e o “alarme interno” dispara.
Só que esse estado bate de frente com o que o organismo precisa para dormir: activação a diminuir, mais melatonina, pulso a baixar. Quando o treino forte termina tarde, esse processo natural empurra-se para a frente - e você fica acordado por muito mais tempo, mesmo querendo dormir.
“Treino intenso pouco antes de dormir funciona para pouquíssimas pessoas - a cabeça está na cama, mas o corpo ainda está em modo competição.”
Isso significa que é preciso cortar o exercício à noite? Não. A chave é ajustar o tipo de treino ao horário.
Sessões suaves: como carga leve pode ajudar a adormecer
Para o fim da noite, o melhor costuma ser o que estimula a circulação, mas sem levar o corpo ao limite. Bons exemplos:
- caminhada rápida ou corrida leve e confortável
- bicicleta num ritmo solto, sem pressão por desempenho
- natação em ritmo constante, em vez de séries de sprints
- yoga, especialmente estilos mais calmos, com foco em alongamento e respiração
- pilates ou treino funcional com carga moderada
- alongamento puro ou sessões de mobilidade
Essas opções favorecem o sistema de recuperação do corpo, a parte parassimpática do sistema nervoso. A respiração aprofunda, o tónus muscular reduz e a tensão interna começa a soltar. São sinais que colaboram com a preparação para a noite.
Coruja ou madrugador: como o seu ritmo muda tudo
Cronótipo: por que nem toda a gente “combina” com treino tarde
As pessoas não funcionam iguais ao longo do dia. Algumas acordam cedo, rendem muito pela manhã e ficam sonolentas rapidamente à noite. Outras só “engatam” mesmo depois do almoço e mantêm energia mental e física até bem mais tarde.
| Tipo | Disposição típica ao longo do dia | Horário de treino mais indicado |
|---|---|---|
| Tipo matinal | bem disposto de manhã, queda de rendimento à noite | manhã cedo até início da tarde |
| Tipo vespertino | começo lento, pico no fim da tarde/noite | fim da tarde até início da noite |
Quem fica cansado cedo geralmente só “se arrasta” em treinos tardios: o corpo já está a pedir pausa, mas o relógio está a mandar treinar. Isso pode piorar dificuldades para dormir. Já quem é mais ativo à noite costuma tolerar melhor o exercício em horários mais tarde - e muitas vezes aproveita exatamente essa janela.
O que o seu corpo entrega depois do treino
Em vez de seguir regras rígidas, compensa observar como você reage. Perguntas úteis:
- Depois do treino, você fica agradavelmente cansado ou fica elétrico?
- Você adormece em 30–45 minutos ou passa muito tempo a revirar?
- No dia seguinte, acorda recuperado ou com sensação de noite curta?
Para quem quer mais certeza, uma boa estratégia é registar por uma semana: horário, tipo de treino, intensidade, tempo até adormecer e como se sente ao acordar. Assim, padrões aparecem rapidamente, por exemplo: “HIIT depois das 20h não dá certo, mas yoga leve funciona muito bem.”
Temperatura corporal: por que o “calor interno” pode travar o sono
Quando o termóstato do corpo sai do eixo
Antes de adormecer, a temperatura central do corpo cai um pouco. Esse arrefecimento faz parte do “programa do sono”. Já durante o exercício ocorre o inverso: os músculos geram calor, o sangue circula mais depressa, o corpo aquece - e depois precisa de tempo para baixar de novo.
Se você vai para a cama ainda “a ferver”, a tendência é sentir inquietação: chuta a coberta, vira de um lado para o outro, procura a parte fresca do colchão. Nesses casos, não são os pensamentos - é o calor residual que impede o sono de engrenar.
Por que um duche morno é mais inteligente do que um banho gelado
Muita gente sai do treino e toma um banho gelado para “refrescar” rápido. Na hora parece ótimo, mas no corpo o efeito pode ser outro: os vasos sanguíneos contraem, o calor fica mais retido por dentro e o organismo ainda precisa compensar.
“Um duche morno, e não muito demorado, ajuda o corpo a arrefecer bem melhor do que um choque de água gelada.”
Com água quente a morna, os vasos da pele dilatam, o sangue chega mais à superfície e o calor é libertado com mais facilidade depois. Ao secar, a evaporação ainda ajuda a refrescar - uma transição mais suave para o modo noturno.
Timing é tudo: quanto tempo de intervalo antes de dormir faz sentido?
A “zona de duas horas” como guia geral
Muitos especialistas em sono sugerem deixar, no mínimo, duas horas entre o fim do treino e a hora de deitar. Para treinos mais puxados, três horas costumam ser ainda mais confortáveis. Nesse intervalo, o corpo vai desacelerando: a frequência cardíaca desce, a pressão estabiliza, as hormonas entram em equilíbrio e a temperatura cai.
Exemplo prático: se a meta é dormir às 23h, o ideal é que os ténis já estejam guardados entre 20h e 21h - dependendo da intensidade. Já uma caminhada tranquila de 30 minutos ou um alongamento leve normalmente permitem empurrar um pouco esse limite, conforme a pessoa.
O que colocar no prato depois do treino
O jantar também entra na equação. Uma refeição muito grande e rica em gordura logo após o exercício mantém a digestão e a circulação “trabalhando” por bastante tempo - e isso aparece na cama. Por outro lado, comer pouco demais pode provocar fome forte ou queda de açúcar durante a noite.
Costumam ser escolhas fáceis de tolerar:
- uma tigela de iogurte ou queijo cottage com aveia e banana
- pão integral com queijo magro ou peito de peru e alguns legumes
- arroz ou massa integrais com molho leve e legumes
- uma omelete pequena com legumes e uma fatia de pão
Essas combinações trazem proteína para a recuperação, hidratos de carbono complexos para repor energia e não pesam no estômago sem necessidade. E vale distribuir a hidratação ao longo da noite para não acordar a toda hora com vontade de ir ao banheiro.
Como montar o seu plano pessoal de exercício à noite
Mistura individual de intensidade, horário e rituais
O que os dados atuais indicam com bastante consistência é: fazer exercício à noite pode favorecer o sono - desde que a sessão seja moderada, exista intervalo suficiente até a hora de deitar e o cronótipo não seja completamente incompatível. Em vez de uma regra “proibido”, existe uma margem pessoal de ajuste.
Se você não encontra outro horário, não precisa eliminar o treino pós-trabalho de imediato. Em geral, funciona melhor mexer em alguns pontos: baixar a intensidade, colocar sessões muito duras mais cedo, incluir um duche morno e uma refeição leve como parte do plano e reduzir ecrãs depois do treino.
Uma semana de teste pode trazer muita clareza
Se ainda houver dúvida, o melhor é um teste curto: sete dias de treino à noite com intensidade conscientemente ajustada e horário fixo para dormir. Todas as manhãs, anote: quanto demorou para adormecer, quantas vezes acordou e como se sente.
Com isso, fica bem concreto o que funciona. Talvez yoga leve às 20h traga noites excelentes, enquanto um pedal forte depois das 21h leve repetidamente a adormecer tarde. Assim, pouco a pouco, você constrói uma rotina que faz bem ao corpo e ao sono - sem dogmas, mas com efeitos claros e perceptíveis.

Comentários
Ainda não há comentários. Seja o primeiro!
Deixar um comentário